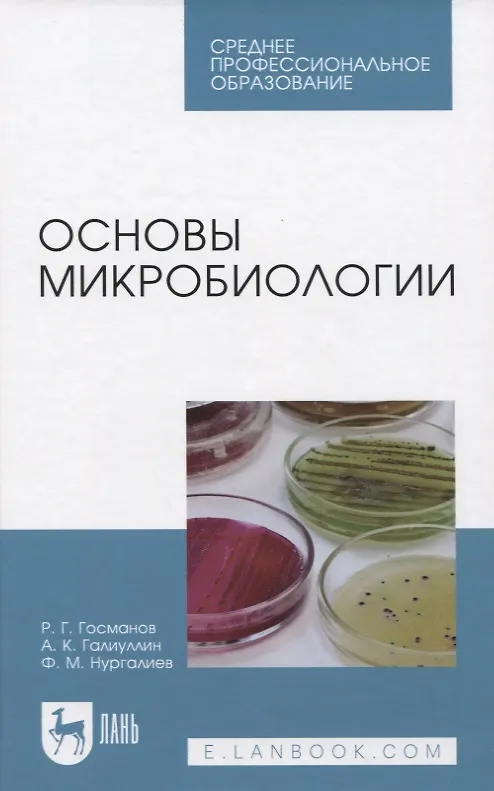

Основы микробиологии. Учебник
33,15 € 24,20 €
Учебник состоит из трех разделов. В первом разделе изложены сведения по морфологии, физиологии, генетике и экологии микроорганизмов, описано значение микроорганизмов в природе, жизни человека и животных, а также превращения микроорганизмами соединений азота и углерода, формы взаимоотношений в мире микробов, антибиотики, влияние факторов внешней среды на микроорганизмы.
Второй раздел посвящен основам учения об инфекции и иммунитете, понятиям патогенности и вирулентности.
Третий раздел — лабораторные занятия — посвящен микробиологическим, культуральным, биохимическим методам исследования, правилам отбора, доставки и хранения биоматериала и серологическим методам диагностики инфекционных болезней животных.
Предназначен для студентов СПО, обучающихся по специальности «Ветеринария».

Доставка 7-28 раб.дней
Доставка 7-28 раб.дней












Отзывы
Пока нет отзывов.